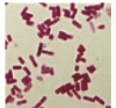

1/66
Looks like no tags are added yet.
Name | Mastery | Learn | Test | Matching | Spaced | Call with Kai |
|---|
No analytics yet
Send a link to your students to track their progress

Which organelle is shown at Number 1?
Flagellum

Which organelle is shown at Number 2?
Ribosomes

Which organelle is shown at number 3?
A Pilus

Which organelle is shown at number 4?
Nucleoid

Which organelle is shown at number 5?
Capsule Layer

Which organelle is shown at number 6?
Cell Wall

Which organelle is shown at number 7?
Plasma Membrane

Which organelle is shown at number 8?
The Cytoplasm

Which organelle is shown at number 9?
A Plasmid

Which organelle is shown at number 1?
Secretory Vesicle

Which organelle is shown at number 2?
Golgi Complex

Which organelle is shown at number 3?
Smooth Endoplasmic Reticulum

Which organelle is shown at number 4?
Chromatin Granules

Which organelle is shown at number 5?
Nucleolus

Which organelle is shown at number 6?
Nuclear Envelope

Which organelle is shown at number 7?
Nucleus

Which organelle is shown at number 8?
Vacuole

Which organelle is shown at number 9?
Lysosome

Which organelle is shown at number 10?
Cilia

Which organelle is shown at number 11?
Plasma Membrane

Which organelle is shown at number 12?
Cytoplasm

Which organelle is shown at number 13?
Microfilaments

Which organelle is shown at number 14?
Ribosome

Which organelle is shown at number 15?
Microtubles

Which organelle is shown at number 16?
Centrioles

Which organelle is shown at number 17?
Mitochondria

Which organelle is shown at number 18?
Rough Endoplasmic Reticulum

Which organelle is shown at number 1?
Rough Endoplasmic Reticulum

Which organelle is shown at number 2?
Nuclear Envelope

Which organelle is shown at number 3?
Chromatin Granules

Which organelle is shown at number 4?
Nucleolus

Which organelle is shown at number 5?
Nucleus

Which organelle is shown at number 6?
Golgi Apparatus

Which organelle is shown at number 7?
Vesicle

Which organelle is shown at number 8?
Cell Wall

Which organelle is shown at number 9?
Cytoplasm

Which organelle is shown at number 10?
Plasma Membrane

Which organelle is shown at number 11?
Mitochondrion

Which organelle is shown at number 12?
Smooth Endoplasmic Reticulum

Which organelle is shown at number 13?
Ribosome

Which organelle is shown at number 14?
Microfilaments

Which organelle is shown at number 15?
Microtubules

Which organelle is shown at number 16?
Chloroplast

Which organelle is shown at number 17?
Central Vacuole

What is the name of this organism?
Stentor

What is the name of this cell?
Elodea

What is the name of this cell?
Human Cheek Cell

What is the name of this kind of bacteria?
Bacilli (Round Bacteria)

What is the name of this cell?
Yeast
What is the name of this bacterium?
Cocci (Rod Bacteria)

What is the name of this cell type?
Amoeba

What is the name of this cell type?
Peranema

What is the name of this bacterium?
Spirili (Spiral Bacteria)

What is the name of this bacterium?
Anabaena (Cyanobacteria)

What are the names of the five Kingdoms/Groups?
Bacteria, Fungi, Protists, Plantae, and Animalia
Which cell has centrioles?
Which cell type has chromatin?
All Three
Which stain color represents a gram-positive bacterium?
Purple Stain
Which stain color represents a gram-negative bacterium?
Pink

What is the name of this bacterium that causes Lyme disease?
Borrelia Burgdorferi
What is the definition of Osmosis?
The diffusion of water across a semipermeable membrane towards an area of high solute concentration.
What is cytosol?
The term used to describe the solution inside a cell
Which solution of permeable in the lab?
The I.K.I
What is Dialysis?
The movement of solutes across a semi-permeable membrane
What is tonicity?
The ability of a solution to make water move in or out of a cell by osmosis.
What color is Starch?
Opaque Clear, Almost White
What color is IKI?
Yellowish